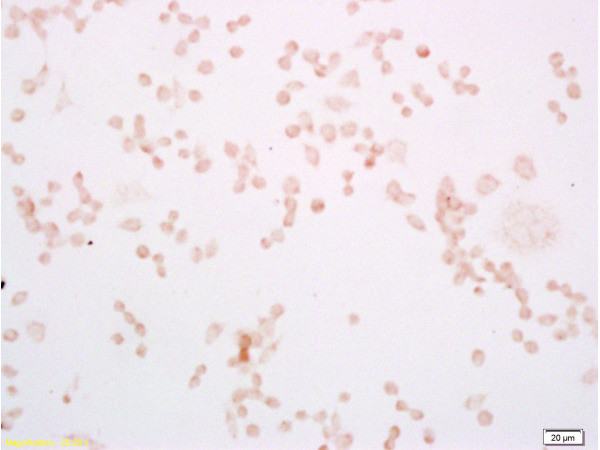
TLR4 Antibody in Immunocytochemistry (ICC/IF)

Search
Bioss
TLR4 Polyclonal Antibody
{{$productOrderCtrl.translations['antibody.pdp.commerceCard.promotion.promotions']}}
{{$productOrderCtrl.translations['antibody.pdp.commerceCard.promotion.viewpromo']}}
{{$productOrderCtrl.translations['antibody.pdp.commerceCard.promotion.promocode']}}: {{promo.promoCode}} {{promo.promoTitle}} {{promo.promoDescription}}. {{$productOrderCtrl.translations['antibody.pdp.commerceCard.promotion.learnmore']}}
产品信息
BS-1021R
种属反应
宿主/亚型
分类
类型
抗原
偶联物
形式
浓度
规格
纯化类型
保存液
内含物
保存条件
运输条件
靶标信息
TLR4 is member of the Toll like receptor (TLR) family which plays a fundamental role in pathogen recognition and activation of innate immunity. TLRs are highly conserved from Drosophila to humans and share structural and functional similarities. This receptor is most abundantly expressed in placenta, and in myelomonocytic subpopulation of the leukocytes. Mammalian cells respond to LPS by activating TLR4. TLR4 belongs to the multi-protein complex of lipopolysaccharide (LPS) receptor, containing CD14, LY96 and TLR4, and is involved in signal transduction events induced by lipopolysaccharide (LPS) found in most gram-negative bacteria. TLR4 aids in the recognition of pathogen-associated molecular patterns (PAMPs) that are expressed on infectious agents, and mediate the production of cytokines necessary for the development of effective immunity. The various TLRs exhibit different patterns of expression. Mutations in the TLR4 gene have been associated with differences in LPS responsiveness. Also, several transcript variants of the TLR4 gene have been found, but the protein coding potential of most of them is uncertain. TLR4 is expressed by peripheral blood monocytes and a small population of B-cells and is also expressed in human placenta. Studies with TLR4-deficient mice indicate that the main ligand for TLR is lipopolysaccharide. Consequently, these mice also showed increased susceptibility to Gram-negative sepsis.
仅用于科研。不用于诊断过程。未经明确授权不得转售。
篇参考文献 (0)
生物信息学
蛋白别名: CD284; homolog of Drosophila toll; hToll; lipopolysaccharide response; similar to the Drosophila Toll protein; LRR motif; similar to the cytoplasmic domain of IL-1 receptor; TLR4; toll like receptor 4 protein; Toll-like receptor 4; toll-like receptor 4 immunity-related protein; Toll4; unnamed protein product
基因别名: ARMD10; CD284; Lps; Ly87; Ran/M1; Rasl2-8; TLR-4; TLR4; TOLL
UniProt ID: (Human) O00206, (Bovine) Q9GL65, (Mouse) Q9QUK6, (Rat) Q9QX05
Entrez Gene ID: (Human) 7099, (Bovine) 281536, (Mouse) 21898, (Rat) 29260